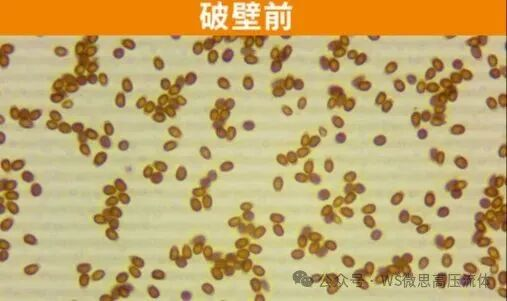

传统中药提取技术存在效率低、有效成分损失大、资源浪费严重等问题。常规粉碎工艺难以彻底破壁植物细胞(如根茎类、种子类药材),导致胞内有效成分释放不足。而高压均质技术通过超高压物理作用,将中药颗粒粉碎至纳米级(平均粒径<1μm),显著提高溶出效率和生物利用度。数据显示,该技术可节省药材30%-70%,缩短提取时间50%以上,成为中药产业升级的关键技术。
高速剪切破壁
物料在100-150 MPa高压下通过均质阀,剪切力瞬间击穿细胞壁,释放黄酮、多糖等活性成分。
图2 均质原理图
空穴效应增效
压力骤降产生的空化气泡爆破,进一步撕裂细胞结构,提升溶剂渗透效率。
低温纳米分散
内置冷却系统精准控温,避免热敏成分(如阿魏酸、龙脑)挥发,颗粒粒径降至100-500 nm,比表面积增大10倍,溶出速率提高3倍。
高效破壁
灵芝孢子粉经高压均质破壁后,破壁率>98%(传统研磨仅70%),抗肿瘤活性提升40%。
破壁率与使用设备的次数和压力呈正相关
精准控效
柴达木枸杞叶提取芦丁时,高压均质法含量较回流法、超声法提升23%,且无需加热,活性保留率超95%。
绿色节能
WS工业级机型能耗较传统设备降低35%,碳排放减少20%,支持4000L/H连续化生产。
与传统方法相比,高压均质机有哪些优势:
未来可能的发展方向:协同增效工艺:高压均质与超声波、微波预处理联用,提取率再提高15%-30%。